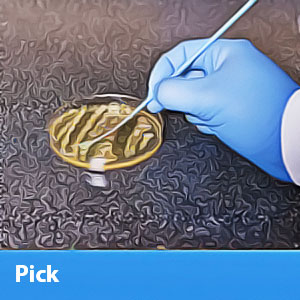

๐ Test with Confidence: The Future of Indole Testing is Here!
The Indole, DMACA Spot Test by Hardy Diagnostics is a 15ml dropper vial designed for rapid indole testing on filter paper. It provides quick and reliable results, with a positive reaction indicated by a striking blue to blue-green color change within just 10 seconds.

Trustpilot
2 months ago
3 weeks ago
3 weeks ago
2 weeks ago